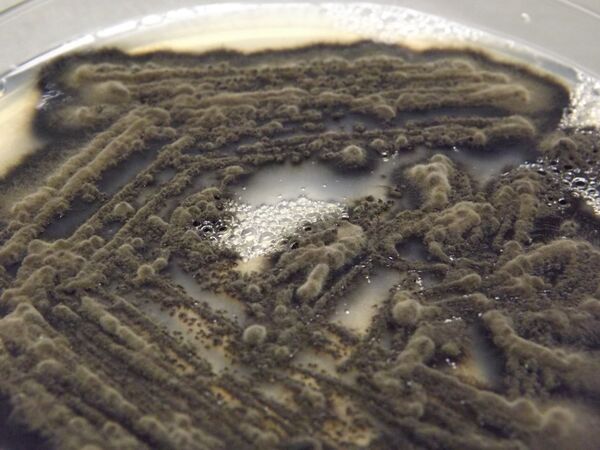
El superalimento chileno a base de algas marinas y hongos El superalimento chileno a base de algas marinas y hongos - Sputnik Mundo

La idea surgió a partir de la necesidad de aprovechar la abundante concentración de algas en la costa chilena. Fue con el fin de lograr un producto a partir de esa biomasa marina que la científica Catalina Landeta, Ph. D. en Ingeniería Química y Biotecnología, del Centro de Biotecnología y Bioingeniería (Cebib) de la Universidad de Chile, se encargó del desarrollo de este superalimento. Empezó analizando hongos marinos que pudieran extraer compuestos bioactivos de las algas.
A partir de una investigación científica, llevada a cabo por la profesora María Elena Lienqueo, quien ha trabajado con comunidades locales en diferentes regiones de Chile para aprovechar la biomasa residual de cultivos, bosques y algas, la doctora Landeta inició la selección de los hongos.
Esta investigación ha dado como resultado una micoproteína —proteína derivada de hongos— que potencia en 60% sus proteínas y 42% sus aminoácidos e incrementa la actividad antioxidante, características que lo hacen un muy valoradas por la industria alimentaria, y lo transforman en un superalimento.
"Este ingrediente puede ser usado en cualquier producto alimenticio, aumentando su contenido proteico y otorgando un gran valor nutritivo, posee una baja concentración de grasa y carbohidratos, y es alto en fibra y betaglucanos. Así, Micoseaweed no es solo un ingrediente proteico, también posee compuestos bioactivos con actividad antioxidante, nutraceútica y prebiótica", explica Landeta.

Por tanto, agrega la investigadora, Micoseaweed se puede definir como "un ingrediente proteico de consumo humano altamente nutritivo que combina a través de la fermentación de hongos y algas marinas, la propiedad de estos dos productos benéficos para la salud. Su nombre proviene del griego myco, que significa hongo, y seaweed que significa macroalga en inglés", señala la científica.
Los estudios que permitieron este hallazgo se enmarcan dentro de la línea de investigación y desarrollo del Cebib enfocada en Biorrefinería Azul. Esta Biorrefinería utiliza como materia prima la biomasa de las macroalgas marinas y sus desechos, para obtener productos de mayor valor agregado, como proteínas, antioxidantes, polisacáridos y biocombustibles.
Un proceso sustentable y de bajo costo
Este proceso tiene otra ventaja al ser amigable con el medio ambiente y no requiere grandes gastos energéticos. No se utiliza tierra cultivable, ya que se puede hacer en tanques fermentadores (parecidos a los que se utilizan para la producción de cerveza), y tampoco requiere riego ni se utilizan fertilizantes.
"Con respecto a su elaboración, se utiliza hasta 20 veces menos de agua y 150 veces menos de tierra que en la producción de alimentos de proteína animal. No hay que usar nada de agua dulce, solo agua de mar. No se usa tierra cultivable, no se alteran otros procesos. Además, este alimento puede entrar en lo que es economía circular dado que hemos trabajado con residuos provenientes de distintas empresas", detalla Landeta.
Por tanto, esta solución es económica, explica la investigadora, porque independientemente del clima, ya sea haya inundaciones o sequía, no se utiliza componentes tóxicos ni procesos agresivos, y no implica un gran gasto energético.
Respecto al impacto que este producto pueda tener en el consumidor final, se trata de un alimento de bajo costo con altas propiedades nutricionales, porque está dirigido a aquellas personas que "quieren disminuir o reemplazar el consumo de proteínas de origen animal. Además es un producto que consume poca agua dulce, y poco terreno".
Aportes para la comunidad científica

En la comunidad científica, este hallazgo es importante, afirma la doctora, porque con este estudio se ha logrado caracterizar el crecimiento de este tipo de hongos marinos utilizando algas como sustratos, "pudiendo conocer como es el enriquecimiento en proteínas y aminoácidos en base al consumo de los polisacáridos que contiene y determinar las condiciones óptimas para la producción de estas micoproteínas, que adicionalmente desde este mismo proceso se obtiene una corriente líquida que contiene otras proteínas: hidrofobinas y cerato-plataninas, entre otras, que pueden tener aplicaciones en diversas áreas".
El aumento de la población mundial está comprometiendo de sobremanera la sostenibilidad de los sistemas alimentarios y agrícolas. De tal forma, que la comunidad científica tiene la responsabilidad, opina Landeta, de buscar soluciones tecnológico-innovadoras y aplicables, para disminuir la sobrepresión de los recursos naturales.
En su parecer, las fuentes de proteínas alternativas y sostenibles, como algas y hongos, pueden satisfacer las necesidades nutricionales de los consumidores. Sin embargo, el reto de la comunidad científica "es que estas nuevas fuentes de proteínas se utilicen ampliamente en productos alimenticios, para eso se debe evaluar su biodisponibilidad y garantizar su seguridad para los consumidores".
El futuro de Micoseaweed

Micoseaweed debe pasar a una escala piloto, para comprobar las ventajas del proceso y la calidad del producto. "Aunque hemos hecho pruebas a escala de laboratorio, es necesario hacer pruebas organolépticas independientes para validar la incorporación a otras matrices alimentarias", señala Landeta.
Detalla que también se viene la etapa de certificaciones, aunque aclara que una de las ventajas es que tanto los hongos utilizados y las algas son considerados como sustancias generalmente reconocidas como seguras —GRAS por sus siglas en inglés—, lo que facilita la certificación de las micoproteínas y su incorporación a la alimentación humana.
"Las proyecciones son infinitas, con las propiedades que posee el ingrediente y el formato del producto, creemos que podría ser incorporado a otros alimentos como harinas, alimentos procesados que aporten con alto contenido proteico, ya que su composición y color las hacen muy compatibles para la mezcla con otros productos", precisa la investigadora.
Los siguientes pasos para poner Micoseaweed a disposición del público es la búsqueda de financiamiento para obtener una cantidad de producto mínima viable, para así comenzar a procesar una mayor producción. Lo cierto es que ya se está en conversaciones con una empresa que comercializa algas y se están analizando las posibilidades del producto para su futura comercialización.




